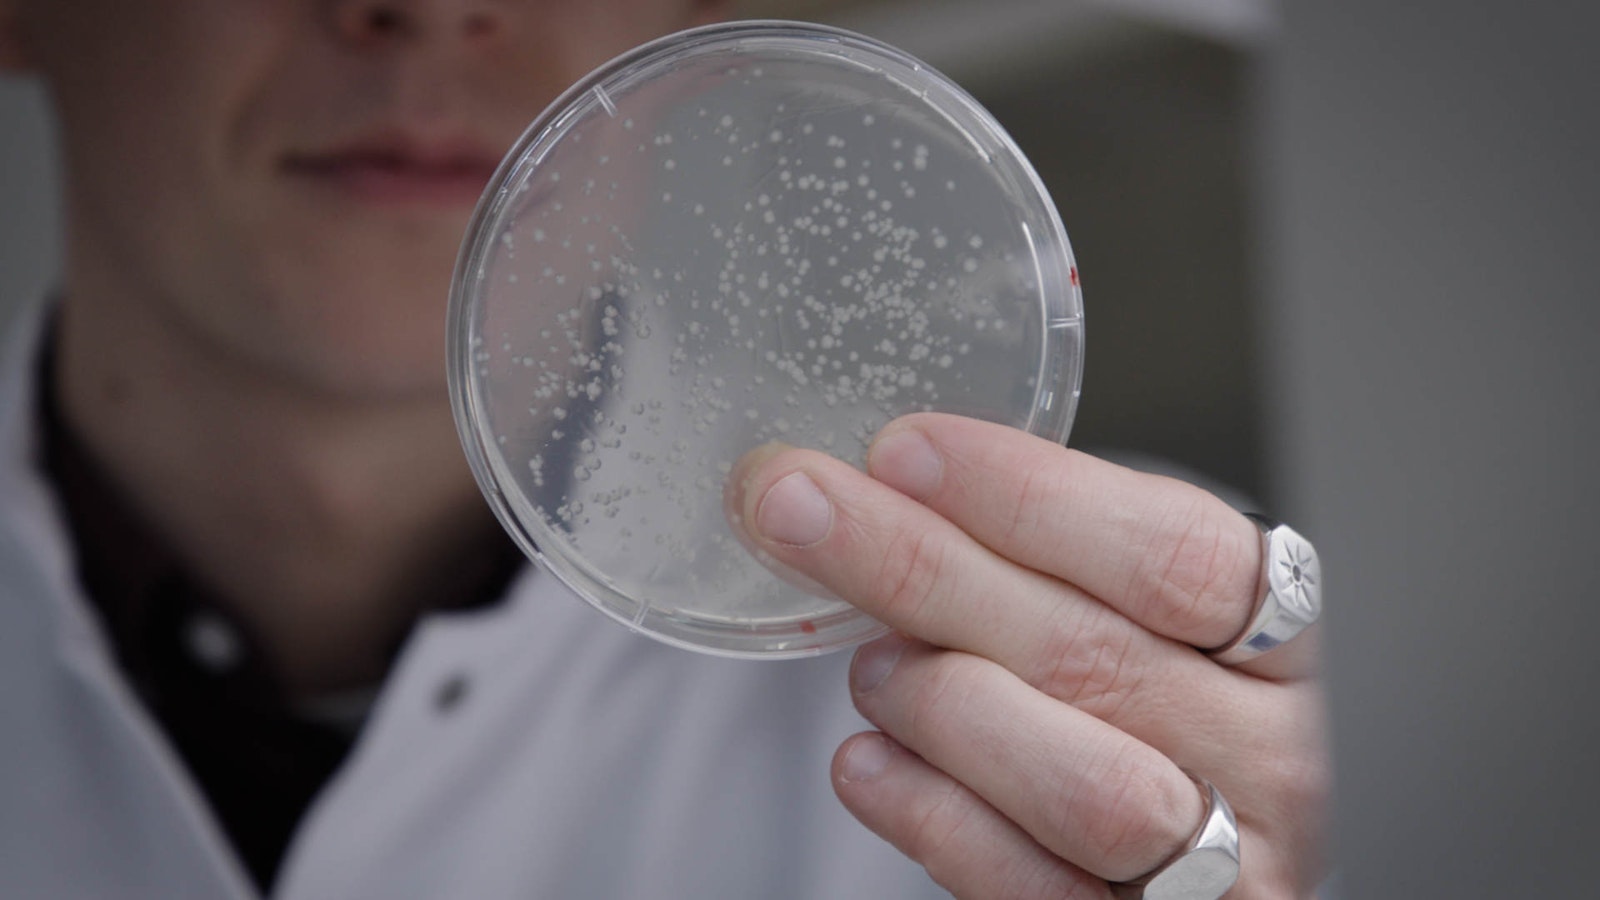

Synobody
Short and sweet
Synobody is a biotech company working within the field of synthetic biology. We have developed a platform that makes the finding and production of a group of molecules called Nanobodies easier and less expensive.
Nanobodies are essential in diagnostics and pharmacology research, and we strive to bridge the gab between researcher and nanobody.
More Info:
Synobody is a synthetic nanobody (Nb) company offering identification and validation of high-affinity nanobodies for research institutions and companies worldwide. The Synobody platform is a highly customizable system developed to ease the implementation into common lab practices independent of application. Although Nbs have huge potential within a wide span of research areas, it has struggled to find its way to market. The necessity of llama immunization and lack of systemization keeps prices high and diminishes ease of adaptation into common lab routines. At Synobody, we want to bridge the gap between Nb-technology and researchers, by addressing these barriers. To eliminate llama immunization, the company has developed a highly diverse and fully synthetic Nb-library used to systematically screen for high-affinity Nb. Identified nanobodies can readily be fused to tags or labels and function with secondary Nb commercially available on the Synobody platform.
| Location | Denmark |
| Website | synobody.com |
| Founded | 2021 |
| Employees | 1-10 |
| Industries | Healthcare & Life Science, Science & Engineering |
| Business model | B2B |
| Funding state | Bootstrapping |
Working at
Synobody
This job comes with several perks and benefits
Skill development
Gym access
Equity package
Team
Founder, CFO
Jannik Faliu
Founder, CSO